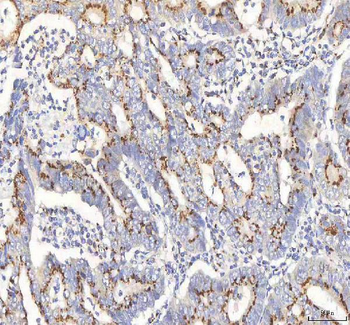
BPNT2 Antibody
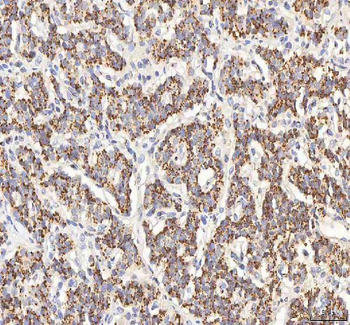
BPNT2 Antibody
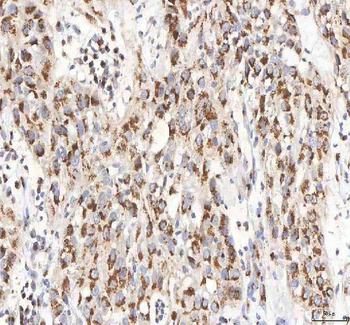
BPNT2 Antibody
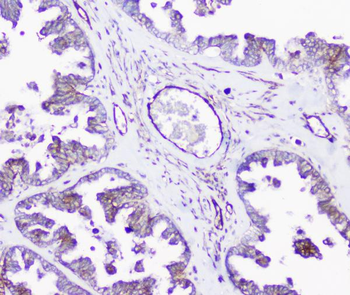
INPPL1 Antibody

You have no items in your shopping cart.
Inositol
Description
Images & Validation
−| Application Notes |
|---|
Key Properties
−| CAS Number | 6917-35-7 |
|---|---|
| MW | 180.16 |
| Purity | ≥98% |
| Formula | C6H12O6 |
| SMILES | C1(C(C(C(C(C1O)O)O)O)O)O |
| Solubility | Soluble in water. Slightly soluble in alcohol. Insoluble in common organic solvents. |
Storage & Handling
−| Storage | Storage Temp: Ambient |
|---|---|
| Hazard Information | UN Number: Not dangerous goods |
| Disclaimer | For research use only |
Alternative Names
−Similar Products
−BPNT2 Antibody [orb1819424]
ELISA, FC, ICC, IF, IHC, WB
Human, Mouse, Rat
Rabbit
Polyclonal
Unconjugated
100 μgINPPL1 Antibody [orb443189]
ELISA, FC, ICC, IF, IHC, WB
Human, Mouse, Rat
Rabbit
Polyclonal
Unconjugated
100 μgAnnexin A3/ANXA3 Antibody [orb259597]
ICC, IHC, WB
Human, Mouse, Rat
Rabbit
Polyclonal
Unconjugated
100 μgPhospho-IRE1a (Ser 726) Rabbit Polyclonal Antibody [orb157704]
FC, IF, IHC-Fr, IHC-P
Bovine, Canine, Equine, Mouse, Porcine, Rabbit
Human, Rat
Rabbit
Polyclonal
Unconjugated
50 μl, 100 μl, 200 μlIP3 receptor/ITPR1 Antibody [orb215979]
FC, ICC, IF, IHC, WB
Human, Mouse, Rat
Rabbit
Polyclonal
Unconjugated
100 μg

Quality Guarantee
Explore bioreagents carefree to elevate your research. All our products are rigorously tested for performance. If a product does not perform as described on its datasheet, our scientific support team will provide expert troubleshooting, a prompt replacement, or a refund. For full details, please see our Terms & Conditions and Buying Guide. Contact us at support@biorbyt.com.

Compound Identifiers
Key Properties
−Documents Download
Request a Document
Protocol Information
Inositol (orb320483)
Participating in our Biorbyt product reviews program enables you to support fellow scientists by sharing your firsthand experience with our products.
Login to Submit a Review